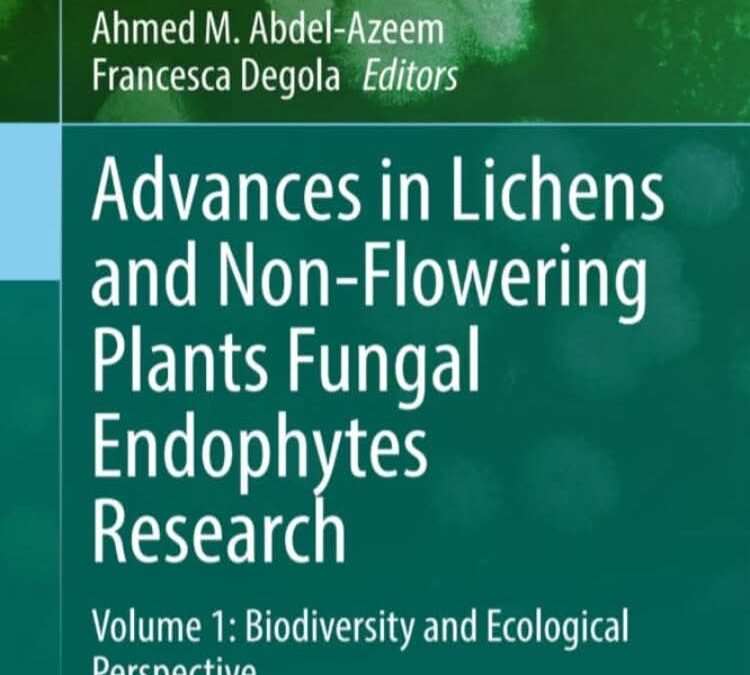

أسهم عدد من تدريسيي قسم علوم الحياة بكلية التربية للعلوم الصرفة في جامعة الحمدانية في تأليف فصلين علميين ضمن كتاب صدر حديثًا عن دار النشر الألمانية Springer، بعنوان:“Advances in Lichens and Non-Flowering Plants Fungal Endophytes Research” – Volume 1: Biodiversity and Ecological Perspective.جاء الفصل الأول بعنوان:“Discovery of Endo-Fungi within Water Ferns: Community Analyses Based on High Throughput Sequencing”أما الفصل الثاني فكان بعنوان:“Biodiversity of Algicolous Fungi Related with Macroalgae (Seaweeds)”ويُعد هذا الإنجاز العلمي إضافة نوعية إلى النتاج البحثي لكلية التربية للعلوم الصرفة، إذ يعكس المستوى العلمي لتدريسييها، ويجسد التعاون البحثي المثمر بين جامعة الحمدانية والجامعات الأخرى، بما يُعزز مكانة الجامعة في الساحة الأكاديمية والبحثية على المستويين المحلي والدولي.